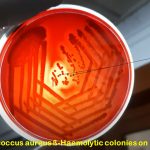

Tag: Introduction of Blood Agar (BA)
Blood Agar (BA): Introduction, Composition, Preparation, Principle and Interpretation, Uses , Types of Hemolysis and Keynotes
 Introduction of Blood Agar (BA) Blood agar (BA) is an...
Introduction of Blood Agar (BA) Blood agar (BA) is an...
Introduction of Blood Agar (BA) Blood agar (BA) is an...
Introduction of Blood Agar (BA) Blood agar (BA) is an...